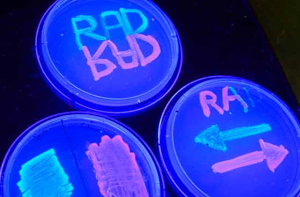

据物理学家组织网5月21日报道,斯坦福大学生物工程系的科学家创建了一种新系统,能够重复编码、擦写和储存活体细胞DNA中的数据。他们表示,可编程的数据存储在活体细胞的DNA内,或可成为研究癌症、衰老和有机体发展等的强大工具。相关研究报告发表在同日出版的美国《国家科学院学报》上。
虽然基因物质本身就具备天然的数据存储介质,但支持科学家可靠且可逆地将信息写入活体DNA的工具仍十分匮乏。以前的研究虽可通过单个酶的表达朝一个方向翻转基因序列,但这一过程并不可逆,而科研人员需要不断翻转基因序列以创建可完全重复使用的数据存储器。
科学家坦言,虽然翻转DNA的截面至两个方向之一并不困难,但获取蛋白质水平的平衡却非易事。为了使新系统正常工作,研究团队需要精确控制微生物内两个对立蛋白质、整合酶和切除酶的动态。
他们经过3年多达750次的尝试,最终成功创建了相当于1比特(1位)的基因物质。相关人员解释说,如果DNA的截面指向一个方向,它就是0,如果指向另一个方向,其就是1。由此,科研人员能计算出细胞分裂的次数,这或将赋予科学家制止细胞癌变发生的能力。
研究小组将这款设备命名为“重组酶可寻址数据”模块(RAD)。RAD可借助改编自噬菌体的丝氨酸和切除酶来按需翻转和还原特定的DNA序列。这将形成类似于计算机领域的“永久性数据存储”,能在无功耗的情况下保留信息。随后,科研小组在单个微生物内对RAD模块进行了测试,其在缺乏基因表达的情况下也能被动存储信息,十分可靠。此外,它们能重复切换而不使性能发生退化,使科学家目睹细胞分裂100余次,这对支持组合化的数据存储十分重要。
研究人员表示,他们未来的目标是尽快创建可扩展的、可靠的生物位,实现1字节的可编程基因数据的存储,随后再逐步挖掘基因数据存储更广泛的应用范围。(来源:科技日报 张巍巍)
特别声明:本文转载仅仅是出于传播信息的需要,并不意味着代表本网站观点或证实其内容的真实性;如其他媒体、网站或个人从本网站转载使用,须保留本网站注明的“来源”,并自负版权等法律责任;作者如果不希望被转载或者联系转载稿费等事宜,请与我们接洽。